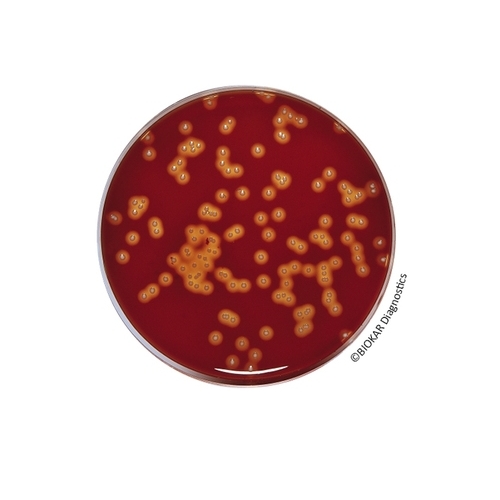
Tryptone-Soy Agar

Tryptone-Soy Agar
Tryptone-Soy Agar, used as a base to be supplemented with blood, is prepared with selected starting materials which do not turn brown. It was specially designed to detect beta-hemolytic reactions and to favor the growth of particularly fastidious aerobic and anaerobic bacteria. The media can be used for the hemolysis test on presumed colonies of Bacillus cereus, according to the standard ISO 21871.